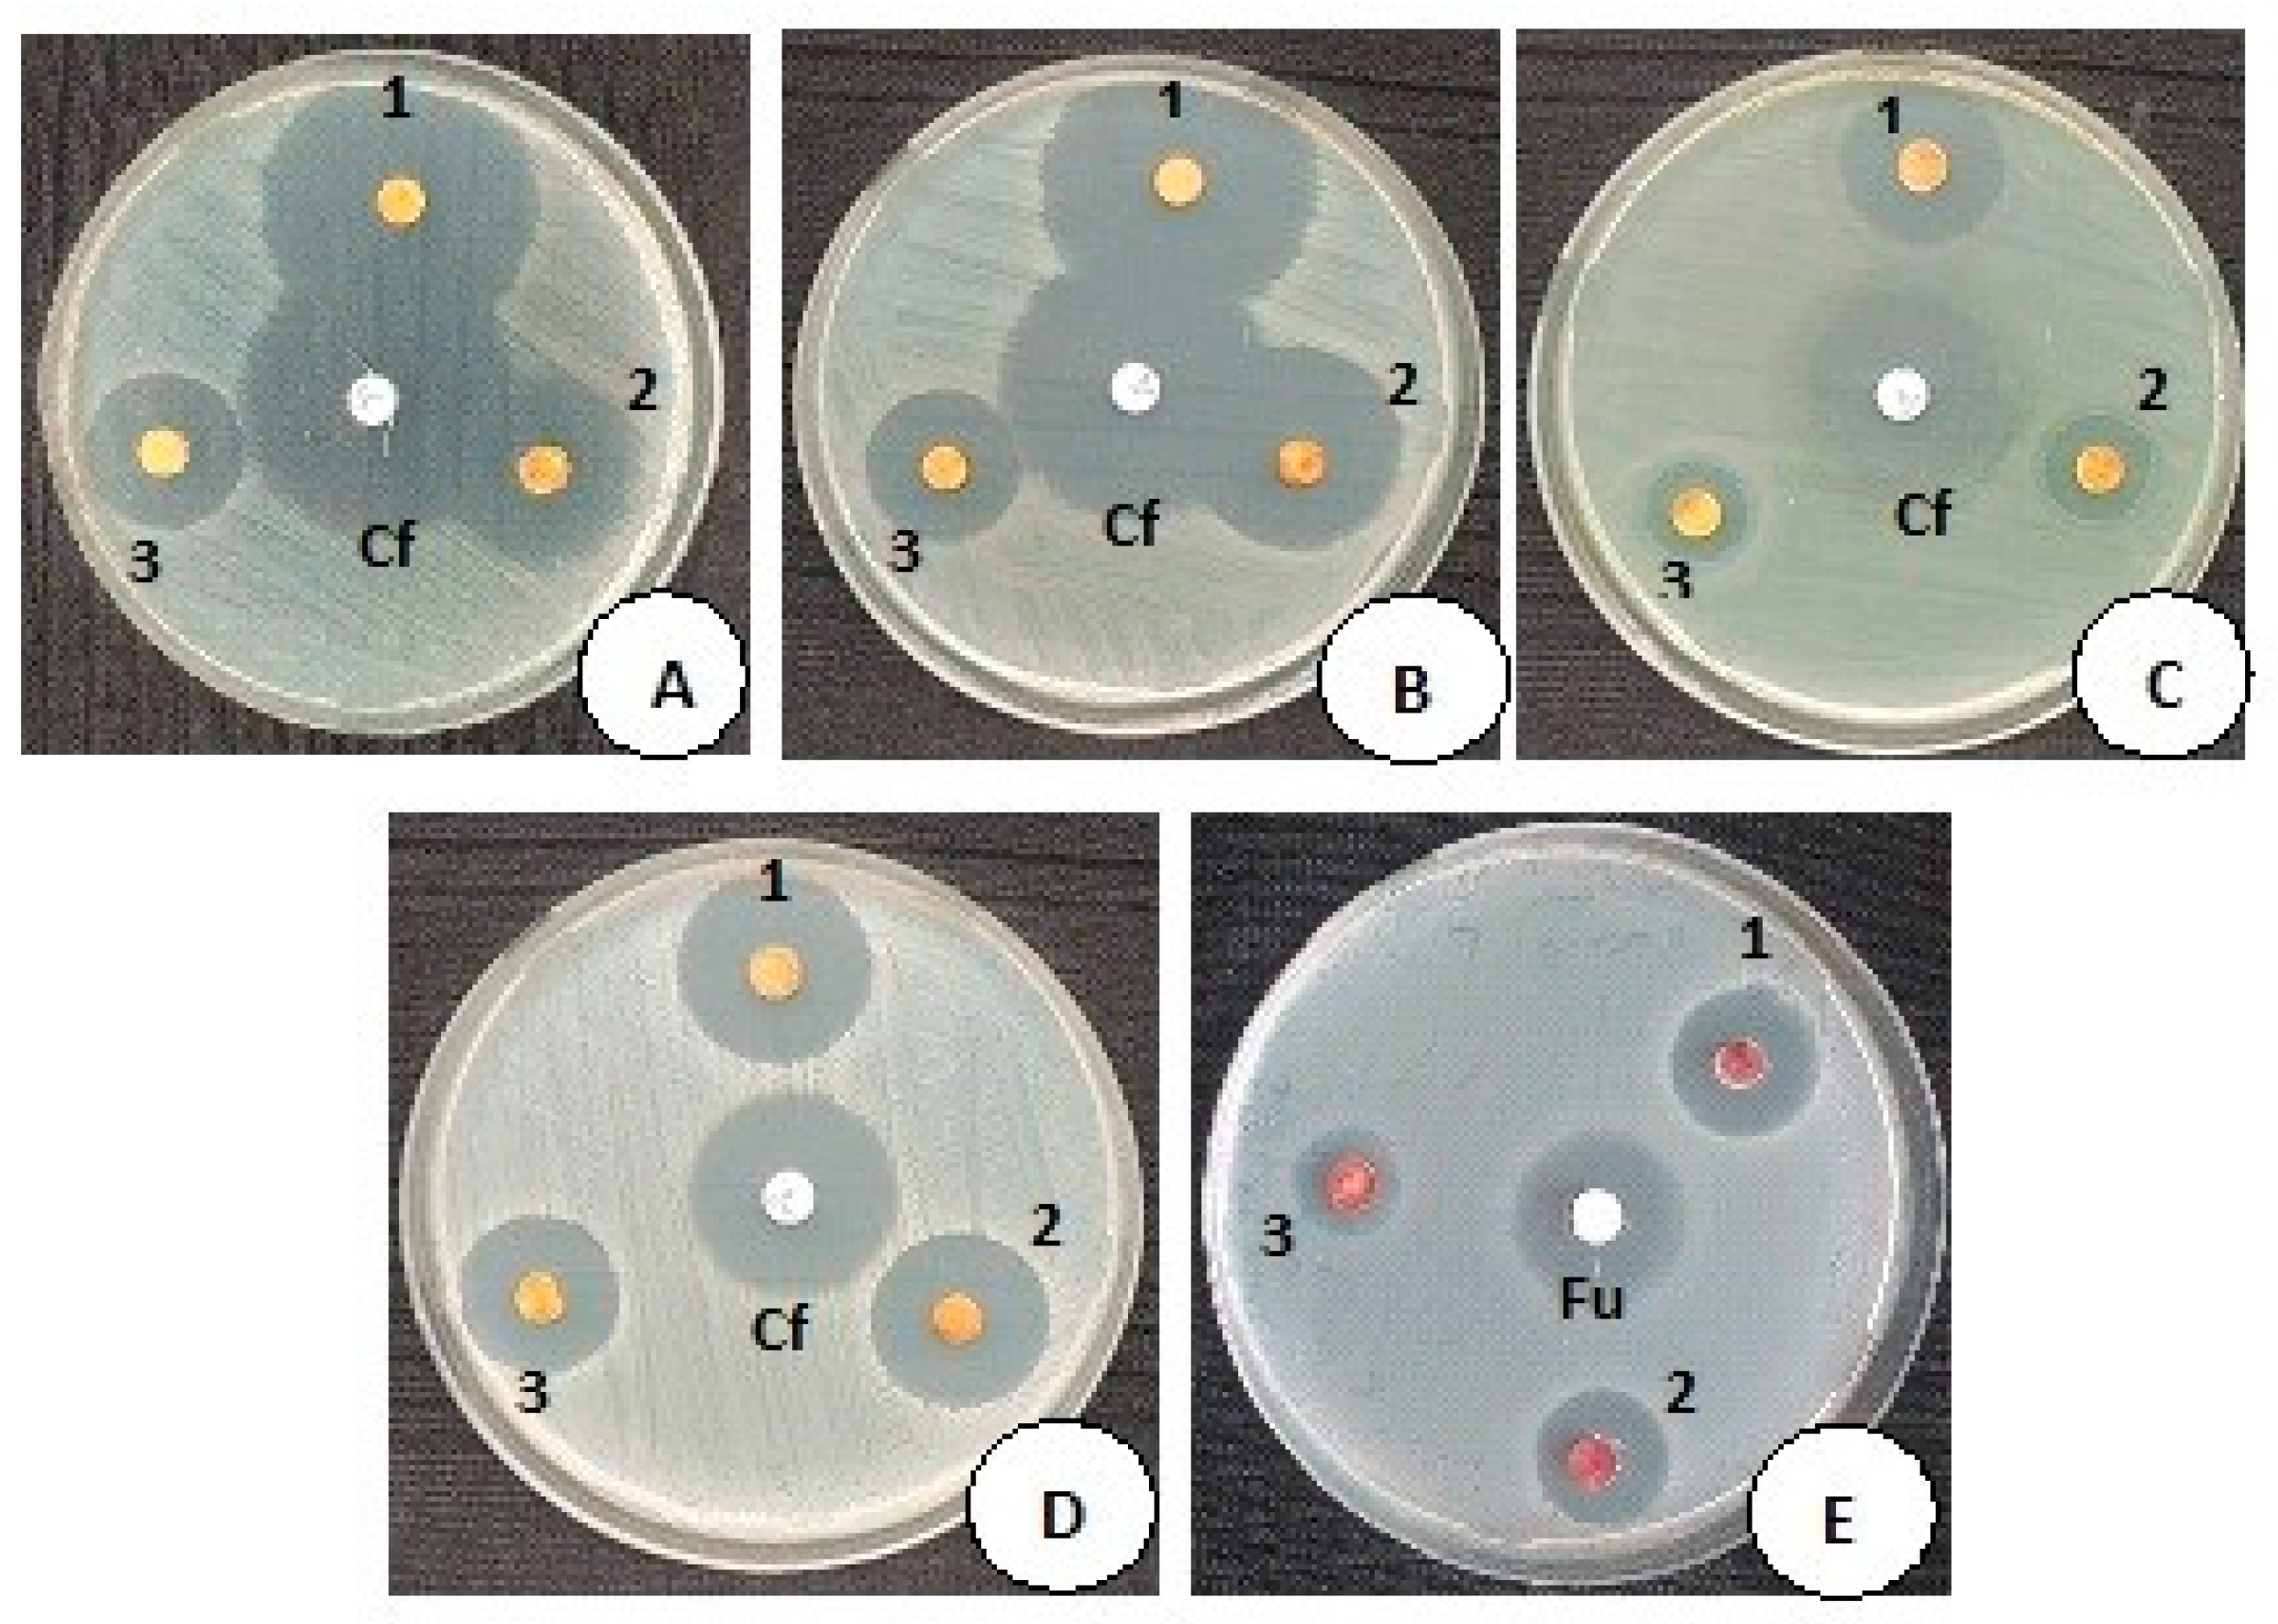
Nanomaterials 13 01227 g004

Biopolymer Chitosan Surface Engineering with Magnesium Oxide-Pluronic-F127-Escin Nanoparticles on Human Breast Carcinoma Cell Line and Microbial Strains
Abstract
1. Introduction
2. Materials and Methods
2.1. Materials
2.2. Preparation of MgO-Chitosan-Pluronic F127-Escin NPs
2.3. Characterization of MgO-Chitosan-Pluronic F127-Escin NPs
2.4. Evaluation of Antimicrobial Efficacy
2.5. In Vitro Anticancer Activity of MgO-Chitosan-Pluronic F127-Escin NPs
2.5.1. Maintenance of MDA-MB-231 Cell Lines
2.5.2. Cytotoxicity Assay
2.5.3. Analysis of Apoptotic Cells by Dual Staining Approach
2.5.4. Evaluation of Mitochondrial Membrane Potential (Δψm) by JC-1 (5,5′,6,6′-TetraChloro-1,1′,3,3′-Tetraethyl-Benzimidazolyl Carbocyanine Iodide) Staining
2.5.5. Detection of Reactive Oxygen Species (ROS) by DCFH–DA (Dichloro-Dihydro-Fluorescein Diacetate) Staining
2.5.6. Analysis of Cell Morphology by DAPI (4′,6-Diamidino-2-Phenylindole) Staining
2.6. Statistical Analysis
3. Results and Discussion
3.1. Characterization of Green MgO-Chitosan-Pluronic F127-Escin NPs
3.1.1. UV-Visible Spectroscopy
3.1.2. FTIR Spectroscopic Analysis
3.1.3. PL Spectrum
3.2. X-ray Diffraction Examination
3.3. Dynamic Light Scattering (DLS) Analysis
3.4. Morphology and Chemical Composition
3.5. Antimicrobial Activity of MCsPFE NPs
3.6. Anticancer Activity of MgO-Chitosan-Pluronic F127-Escin NPs by Cytotoxicity Assay
3.7. Evaluation of Apoptosis by AO/EB Dual Staining
3.8. Analysis of Δψm by JC-1 Staining
3.9. Detection of ROS by DCFH–DA Staining
3.10. DAPI Staining
4. Conclusions
Author Contributions
Funding
Data Availability Statement
Acknowledgments
Conflicts of Interest
References
- Shaukat, A.; Anwar, H.; Mahmood, A.; Hussain, G.; Rasul, A.; Ijaz, M.U.; Faisal, M.N.; Ibrahim, M.; Ali, A. Synthesis cum characterization of MgO and MnO nanoparticles and their assessment as antidiabetic and antioxidative agents in diabetic rat model. Phys. B Condens. Matter 2021, 602, 412570. [Google Scholar] [CrossRef]
- Sharma, G.; Soni, R.; Jasuja, N.D. Phytoassisted synthesis of magnesium oxide nanoparticles with Swertia chirayaita. J. Taibah Univ. Sci. 2017, 11, 471–477. [Google Scholar] [CrossRef]
- Sierra-Fernandez, A.; De la Rosa-García, S.C.; Gomez-Villalba, L.S.; Gómez-Cornelio, S.; Rabanal, M.E.; Fort, R.; Quintana, P. Synthesis, photocatalytic, and antifungal properties of MgO, ZnO and Zn/Mg oxide nanoparticles for the protection of calcareous stone heritage. ACS Appl. Mater. Interfaces 2017, 9, 24873–24886. [Google Scholar] [CrossRef] [PubMed]
- Parthiban, E.; Manivannan, N.; Ramanibai, R.; Mathivanan, N. Green synthesis of silver-nanoparticles from Annona reticulata leaves aqueous extract and its mosquito larvicidal and anti-microbial activity on human pathogens. Biotechnol. Rep. 2019, 21, e00297. [Google Scholar] [CrossRef]
- Tahvilian, R.; Zangeneh, M.M.; Falahi, H.; Sadrjavadi, K.; Jalalvand, A.R.; Zangeneh, A. Green synthesis and chemical characterization of copper nanoparticles using Allium saralicum leaves and assessment of their cytotoxicity, antioxidant, antimicrobial, and cutaneous wound healing properties. Appl. Organomet. Chem. 2019, 33, e5234. [Google Scholar] [CrossRef]
- He, Y.; Ingudam, S.; Reed, S.; Gehring, A.; Strobaugh, T.P.; Irwin, P. Study on the mechanism of antibacterial action of magnesium oxide nanoparticles against foodborne pathogens. J. Nanobiotechnol. 2016, 14, 54. [Google Scholar] [CrossRef]
- Ealia, S.A.M.; Saravanakumar, M.P. November. A review on the classification, characterisation, synthesis of nanoparticles and their application. In IOP Conference Series: Materials Science and Engineering; IOP Publishing: Philadelphia, PA, USA, 2017; Volume 263, No. 3; p. 032019. [Google Scholar]
- Sirota, V.; Selemenev, V.; Kovaleva, M.; Pavlenko, I.; Mamunin, K.; Dokalov, V.; Prozorova, M. Synthesis of magnesium oxide nanopowder by thermal plasma using magnesium nitrate hexahydrate. Phys. Res. Int. 2016, 2016, 6853405. [Google Scholar] [CrossRef]
- Ramanujam, K.; Sundrarajan, M. Antibacterial effects of biosynthesized MgO nanoparticles using ethanolic fruit extract of Emblica officinalis. J. Photochem. Photobiol. B Biol. 2014, 141, 296–300. [Google Scholar] [CrossRef] [PubMed]
- Cai, L.; Chen, J.; Liu, Z.; Wang, H.; Yang, H.; Ding, W. Magnesium oxide nanoparticles: Effective agricultural antibacterial agent against Ralstonia solanacearum. Front. Microbiol. 2018, 9, 790. [Google Scholar] [CrossRef]
- Niculescu, A.G.; Grumezescu, A.M. Applications of chitosan-alginate-based nanoparticles—An up-to-date review. Nanomaterials 2022, 12, 186. [Google Scholar] [CrossRef] [PubMed]
- Kazachenko, A.S.; Akman, F.; Malyar, Y.N.; Issaoui, N.; Vasilieva, N.Y.; Karacharov, A.A. Synthesis optimization, DFT and physicochemical study of chitosan sulfates. J. Mol. Struct. 2021, 1245, 131083. [Google Scholar] [CrossRef]
- Vu-Quang, H.; Vinding, M.S.; Nielsen, T.; Ullisch, M.G.; Nielsen, N.C.; Nguyen, D.T.; Kjems, J. Pluronic F127-folate coated super paramagenic iron oxide nanoparticles as contrast agent for cancer diagnosis in magnetic resonance imaging. Polymers 2019, 11, 743. [Google Scholar] [CrossRef] [PubMed]
- Waheed, H.J.; Nashtar, S.B.; Al-Gareeb, A.I.; Al-Kuraishy, H.M. Neurobehavioral Effects of β-Escin. Curr. Psychopharmacol. 2019, 8, 79–86. [Google Scholar] [CrossRef]
- Idris, S.; Mishra, A.; Khushtar, M. Phytochemical, ethanomedicinal and pharmacological applications of escin from Aesculus hippocastanum L. towards future medicine. J. Basic Clin. Physiol. Pharmacol. 2020, 10, 31. [Google Scholar] [CrossRef] [PubMed]
- Shamprasad, B.R.; Keerthana, S.; Megarajan, S.; Lotha, R.; Aravind, S.; Veerappan, A. Photosynthesized escin stabilized gold nanoparticles exhibit antidiabetic activity in L6 rat skeletal muscle cells. Mater. Lett. 2019, 241, 198–201. [Google Scholar] [CrossRef]
- Elderdery, A.Y.; Alhamidi, A.H.; Elkhalifa, A.M.; Althobiti, M.M.; Eltayeb Omer, N.; Alsugoor, M.H.; Alsuhaymi, N.; Atebien, E.M.; Hamza, S.M.; Alzahrani, B.; et al. Synthesis, Characterization, and Antimicrobial and Antiproliferative Effects of CuO-TiO2-Chitosan-Escin Nanocomposites on Human Leukemic MOLT4 Cells. Nanomaterials 2022, 12, 3753. [Google Scholar] [CrossRef] [PubMed]
- Rao, K.G.; Ashok, C.H.; Rao, K.V.; Chakra, C.S.; Akshaykranth, A. Eco-friendly synthesis of MgO nanoparticles from orange fruit waste. Int. J. Appl. Phys. Sci. 2015, 2, 1–6. [Google Scholar]
- Sharmila, G.; Muthukumaran, C.; Sangeetha, E.; Saraswathi, H.; Soundarya, S.; Kumar, N.M. Green fabrication, characterization of Pisonia alba leaf extract derived MgO nanoparticles and its biological applications. Nano-Struct. Nano-Objects 2019, 20, 100380. [Google Scholar] [CrossRef]
- Vidhya, E.; Vijayakumar, S.; Nilavukkarasi, M.; Punitha, V.N.; Snega, S.; Praseetha, P.K. Green fabricated MgO nanoparticles as antimicrobial agent: Characterization and evaluation. Mater. Today: Proc. 2021, 45, 5579–5583. [Google Scholar] [CrossRef]
- Jain, S.; Mehata, M.S. Medicinal plant leaf extract and pure flavonoid mediated green synthesis of silver nanoparticles and their enhanced antibacterial property. Sci. Rep. 2017, 7, 15867. [Google Scholar] [CrossRef]
- Branca, C.; Khouzami, K.; Wanderlingh, U.; D’Angelo, G. Effect of intercalated chitosan/clay nanostructures on concentrated pluronic F127 solution: A FTIR-ATR, DSC and rheological study. J. Colloid Interface Sci. 2018, 517, 221–229. [Google Scholar] [CrossRef]
- Bolton, J.D.; Henderson, B.; O’connell, D.O. Photoluminescence of F2+ 2 centres in additively coloured magnesium oxide. Solid State Commun. 1981, 38, 287–290. [Google Scholar] [CrossRef]
- Zhang, J.; Zhang, L. Intensive green light emission from MgO nanobelts. Chem. Phys. Lett. 2002, 363, 293–297. [Google Scholar] [CrossRef]
- Yan, W.; Liu, D.; Tan, D.; Yuan, P.; Chen, M. FTIR spectroscopy study of the structure changes of palygorskite under heating. Spectrochim. Acta Part A Mol. Biomol. Spectrosc. 2012, 97, 1052–1057. [Google Scholar] [CrossRef] [PubMed]
- Karthikeyan, C.; Varaprasad, K.; Akbari-Fakhrabadi, A.; Hameed, A.S.H.; Sadiku, R. Biomolecule chitosan, curcumin and ZnO-based antibacterial nanomaterial, via a one-pot process. Carbohydr. Polym. 2020, 249, 116825. [Google Scholar] [CrossRef] [PubMed]
- Borchert, H.; Jürgens, B.; Zielasek, V.; Rupprechter, G.; Giorgio, S.; Henry, C.R.; Bäumer, M. Pd nanoparticles with highly defined structure on MgO as model catalysts: An FTIR study of the interaction with CO, O2, and H2 under ambient conditions. J. Catal. 2007, 247, 145–154. [Google Scholar] [CrossRef]
- Leung, Y.H.; Ng, A.M.; Xu, X.; Shen, Z.; Gethings, L.A.; Wong, M.T.; Chan, C.M.; Guo, M.Y.; Ng, Y.H.; Djurišić, A.B.; et al. Mechanisms of antibacterial activity of MgO: Non-ROS mediated toxicity of MgO nanoparticles towards Escherichia coli. Small 2014, 10, 1171–1183. [Google Scholar] [CrossRef]
- Khan, S.A.; Shahid, S.; Shahid, B.; Fatima, U.; Abbasi, S.A. Green synthesis of MnO nanoparticles using abutilon indicum leaf extract for biological, photocatalytic, and adsorption activities. Biomolecules 2020, 10, 785. [Google Scholar] [CrossRef]
- Levitsky, D.O.; Dembitsky, V.M. Anti-breast cancer agents derived from plants. Nat. Prod. Bioprospecting 2015, 5, 1–16. [Google Scholar] [CrossRef]
- Varghese, E.; Samuel, S.M.; Abotaleb, M.; Cheema, S.; Mamtani, R.; Büsselberg, D. The “yin and yang” of natural compounds in anticancer therapy of triple-negative breast cancers. Cancers 2018, 10, 346. [Google Scholar] [CrossRef]
- Sung, Y.K.; Kim, S.W. Recent advances in polymeric drug delivery systems. Biomater. Res. 2020, 24, 12. [Google Scholar] [CrossRef]
- Pugazhendhi, A.; Prabhu, R.; Muruganantham, K.; Shanmuganathan, R.; Natarajan, S. Anticancer, antimicrobial and photocatalytic activities of green synthesized magnesium oxide nanoparticles (MgONPs) using aqueous extract of Sargassum wightii. J. Photochem. Photobiol. B Biol. 2019, 190, 86–97. [Google Scholar] [CrossRef] [PubMed]
- Karthikeyan, C.; Sisubalan, N.; Sridevi, M.; Varaprasad, K.; Basha, M.H.G.; Shucai, W.; Sadiku, R. Biocidal chitosan-magnesium oxide nanoparticles via a green precipitation process. J. Hazard. Mater. 2021, 411, 124884. [Google Scholar] [CrossRef]
- Celep, A.G.S.; Yilmaz, S.; Coruh, N. Antioxidant capacity and cytotoxicity of Aesculus hippocastanum on breast cancer MCF-7 cells. J. Food Drug. Anal. 2012, 20, 692–698. [Google Scholar]
- Park, S.; Park, J.M.; Park, M.; Ko, D.; Kim, S.; Seo, J.; Nam, K.D.; Jung, E.; Farrand, L.; Kim, Y.J.; et al. β-Escin overcomes trastuzumab resistance in HER2-positive breast cancer by targeting cancer stem-like features. Cancer Cell Int. 2022, 22, 289. [Google Scholar] [CrossRef] [PubMed]
- Khalid, A.; Norello, R.; Abraham, N.A.; Tetienne, J.P.; Karle, J.T.; Lui, C.W.E.; Xia, K.; Tran, A.P.; O’Connor, J.A.; Mann, G.B.; et al. Biocompatible and biodegradable magnesium oxide nanoparticles with in vitro photostable near-infrared emission: Short-term fluorescent markers. Nanomaterials 2019, 9, 1360. [Google Scholar] [CrossRef]
- Ezhilarasan, D. Herbal therapy for cancer: Clinical and experimental perspectives. In Understanding Cancer Therapies; CRC Press: Boca Raton, FL, USA, 2018; pp. 129–166. [Google Scholar]
- Lakshmi, T.; Ezhilarasan, D.; Vijayaragavan, R.; Bhullar, S.K.; Rajendran, R. Acacia catechu ethanolic bark extract induces apoptosis in human oral squamous carcinoma cells. J. Adv. Pharm. Technol. Res. 2017, 8, 143. [Google Scholar]
- Hou, X.S.; Wang, H.S.; Mugaka, B.P.; Yang, G.J.; Ding, Y. Mitochondria: Promising organelle targets for cancer diagnosis and treatment. Biomater. Sci. 2018, 6, 2786–2797. [Google Scholar] [CrossRef]
- Sivandzade, F.; Bhalerao, A.; Cucullo, L. Analysis of the mitochondrial membrane potential using the cationic JC-1 dye as a sensitive fluorescent probe. Bio-Protocol 2019, 9, e3128. [Google Scholar] [CrossRef] [PubMed]
- Ezhilarasan, D.; Apoorva, V.S.; Ashok Vardhan, N. Syzygium cumini extract induced reactive oxygen species-mediated apoptosis in human oral squamous carcinoma cells. J. Oral Pathol. Med. 2019, 48, 115–121. [Google Scholar]
- Abdel-Daim, M.M.; Eissa, I.A.; Abdeen, A.; Abdel-Latif, H.M.; Ismail, M.; Dawood, M.A.; Hassan, A.M. Lycopene and resveratrol ameliorate zinc oxide nanoparticles-induced oxidative stress in Nile tilapia, Oreochromis niloticus. Environ. Toxicol. Pharmacol. 2019, 69, 44–50. [Google Scholar] [CrossRef] [PubMed]
- Ke, Y.; Al Aboody, M.S.; Alturaiki, W.; Alsagaby, S.A.; Alfaiz, F.A.; Veeraraghavan, V.P.; Mickymaray, S. Photosynthesized gold nanoparticles from Catharanthus roseus induces caspase-mediated apoptosis in cervical cancer cells (HeLa). Artif. Cells Nanomed. Biotechnol. 2019, 47, 1938–1946. [Google Scholar] [CrossRef] [PubMed]
- Pajaniradje, S.; Mohankumar, K.; Pamidimukkala, R.; Subramanian, S.; Rajagopalan, R. Antiproliferative and apoptotic effects of Sesbania grandiflora leaves in human cancer cells. BioMed Res. Int. 2014, 2014, 474953. [Google Scholar] [CrossRef] [PubMed]

| Reference ID | Microbial Strains | Control Antibiotic Disc Ciprofloxacin (5 µg) Zone of Inhibition (mm) * | CLSI Reference Range Expected Zone Based on Disc Potency * | 2 mg/mL Zone of Inhibition (mm) | 1.5 mg/mL Zone of Inhibition (mm) | 1 mg/mL Zone of Inhibition (mm) |
|---|---|---|---|---|---|---|
| A | E. coli ATCC:25922 | 34.33 ± 1.41 | 30–40 | 34.33 ± 0.53 | 27.66 ± 0.53 | 22.66 ± 1.06 |
| B | Enterobacter cloacae (Clinical isolate) | 36 ± 0.92 | - | 37.33 ± 0.53 | 26.33 ± 0.53 | 21 ± 0.92 |
| C | P. aeruginosa ATCC:27853 | 32.33 ± 0.53 | 25–33 | 24 ± 0.92 | 17.66 ± 0.53 | 15.66 ± 0.53 |
| D | S. aureus ATCC: 25923 | 25.33 ± 0.53 | 22–30 | 23.66 ± 0.53 | 21.33 ± 0.53 | 19.33 ± 0.53 |
| E | Candida albicans ATCC:10231 (Yeast fungi) | Control antifungal disc Fluconazole (25 µg) 26.33 ±0.53 | 25–30 | 19.33 ± 0.53 | 18.66 ± 1.06 | 16.33 ± 0.53 |
Disclaimer/Publisher’s Note: The statements, opinions and data contained in all publications are solely those of the individual author(s) and contributor(s) and not of MDPI and/or the editor(s). MDPI and/or the editor(s) disclaim responsibility for any injury to people or property resulting from any ideas, methods, instructions or products referred to in the content. |
© 2023 by the authors. Licensee MDPI, Basel, Switzerland. This article is an open access article distributed under the terms and conditions of the Creative Commons Attribution (CC BY) license (https://creativecommons.org/licenses/by/4.0/).
Share and Cite
Mickymaray, S.; Al Aboody, M.S.; Eraqi, M.M.; Alhoqail, W.A.; Alothaim, A.S.; Suresh, K. Biopolymer Chitosan Surface Engineering with Magnesium Oxide-Pluronic-F127-Escin Nanoparticles on Human Breast Carcinoma Cell Line and Microbial Strains. Nanomaterials 2023, 13, 1227. https://doi.org/10.3390/nano13071227
Mickymaray S, Al Aboody MS, Eraqi MM, Alhoqail WA, Alothaim AS, Suresh K. Biopolymer Chitosan Surface Engineering with Magnesium Oxide-Pluronic-F127-Escin Nanoparticles on Human Breast Carcinoma Cell Line and Microbial Strains. Nanomaterials. 2023; 13(7):1227. https://doi.org/10.3390/nano13071227
Chicago/Turabian StyleMickymaray, Suresh, Mohammed Saleh Al Aboody, Mostafa M. Eraqi, Wardah. A. Alhoqail, Abdulaziz S. Alothaim, and Kaviya Suresh. 2023. "Biopolymer Chitosan Surface Engineering with Magnesium Oxide-Pluronic-F127-Escin Nanoparticles on Human Breast Carcinoma Cell Line and Microbial Strains" Nanomaterials 13, no. 7: 1227. https://doi.org/10.3390/nano13071227
APA StyleMickymaray, S., Al Aboody, M. S., Eraqi, M. M., Alhoqail, W. A., Alothaim, A. S., & Suresh, K. (2023). Biopolymer Chitosan Surface Engineering with Magnesium Oxide-Pluronic-F127-Escin Nanoparticles on Human Breast Carcinoma Cell Line and Microbial Strains. Nanomaterials, 13(7), 1227. https://doi.org/10.3390/nano13071227

